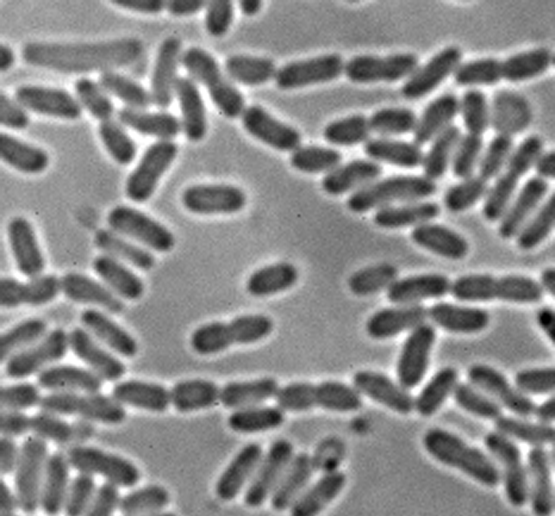
Did you notice one of the cells just disappeared?  ;)

Research
Our research group is interested in the molecular adaptation mechanisms by which bacteria survive in stress environment and interact with competing species. Bacteria have developed complex regulatory networks that control gene expression to respond to different environmental stimuli from the host and the environment. We use cutting-edge genomic tools such as Tn-seq, ChIP-seq, and RNA-seq to characterize key regulators and cognate targets that are important for adaptation under specific environment.
Bacteria often exist in complex communities in nature. An important adaptation strategy in a polymicrobial environment is to attack competing species for invasion or self-defense through delivery of toxic molecules. We study the Type Six Secretion System (T6SS) that exists in 25% Gram-negative bacteria including many human pathogens including Vibrio cholerae, Pseudomonas aeruginosa, and Salmonella species. T6SS is analogous to an inverted bacteriophage tail. T6SS injects antibacterial or anti-eukaryotic effectors to target cells through direct contact. We are interested in characterizing T6SS-dependent effectors and their contribution to fitness and interaction with eukaryotic and prokaryotic competitors.
Our group is actively involved in the Advancing Canadian Wastewater Assets (ACWA) project. ACWA is a multi-million CFI-funded joint project between the city of Calgary and the UofC focusing on water research. We are the anchor group in the ACWA Microbial Research Laboratory. We are interested in understanding how the microbial community responds to wastewater treatment and whether our current strategy is effective in preventing the spread of waterborne pathogens and transfer of genetic materials including genes for virulence and antimicrobial resistance.
Antagonistic interactions between two killer species
Our first try of capturing the interaction between a microbe and a eukaryote.

Detection of ROS in E. coli treated with polymyxin B. ROS levels were detected using CM-H2DCFDA (10 uM). (A), polymyxin B treated E. coli. (B), E. coli treated with PBS.

A GFP-labelled protein lights up the periplasm.

Do you see the glow? T6S everywhere...
Did you notice one of the cells just disappeared? ;)

Trip to the Bonnybrook Wastewater Treatment Plant and inside the UV treatment building. See the massive UV-bulb arrays. Can you believe this facility was under water during the 2013 flood?